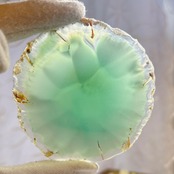

1/5
【E9688】メノウスライス*めのう*着色*瑪瑙*アゲート *Agate*スライス
¥1,200
SOLD OUT
コースターやインテリア、結婚式の席札としても人気です。
【使用ストーン】
めのう(着色)
約80㎜×75㎜×4㎜
産地:ブラジル
*・゜゚・*・*:.。. .。.:*・゜゚・* *・゜゚・*・*:.。. .。.:*・゜゚・* ・* こちらの商品は店舗や他サイトにて同時に販売しております。 そのため、稀にご注文いただいた時点で、品切れになってしまうこともあります。 大変申し訳ございませんが、その場合はご連絡後、キャンセルとさせていただきます。ご迷惑をおかけしますが ご了承のほどよろしくお願い致します* ・* ゜゚・*:.。..。.:*.。. .。.:** ・* ゜゚・*:.。..。.:*.。. .。.:*
【配送について】
プチプチに包んで発送致します。
【ビーズについて 】
・サイズはおおよそになります。ものにより若干(±0.5mm程度)の誤差がある場合がございます。 ・写真に写らない小さなキズ、内包物等がある場合がございます。
・なるべく実物に近い色合いになるように撮影していますが、お使いのモニターによっては実際の色と若干異なる事もございます。
-
レビュー
(1337)
最近チェックした商品
同じカテゴリの商品
セール中の商品
その他の商品
Category